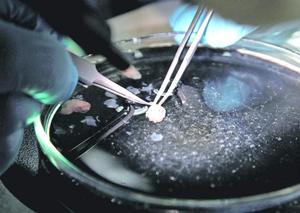

Más leídas
Opinión | Pág. 2
#Brereton

Reportajes | Pág. 8
Virgin Galactic iniciará vuelos comerciales al espacio este mes

Economía y empresas | Pág. 11
Innovación y desempeño de las empresas

Nacional | Pág. 10
Tres hermanos se reencuentran tras el trágico naufragio en Grecia

Nacional | Pág. 10
Putin recibe a líderes africanos para abordar iniciativa de paz en medio de contraofensiva

Nacional | Pág. 10
El viaje de Blinken a China busca rebajar la tensión, pero las expectativas son bajas

Nacional | Pág. 9
PS exige que Mellado se disculpe con Boric y RN lo califica como "excelente diputado"

Nacional | Pág. 9
Ministro Ávila insiste en que las vacaciones no se adelantan
Nacional | Pág. 9
Francia advierte de posibles sanciones por beneficios excesivos de las empresas

Nacional | Pág. 9
Carlos III preside a caballo su primer cumpleaños oficial como rey británico

Nacional | Pág. 8
Ministra se reúne con familia de San Antonio y advierte de peak de enfermedades en junio

Economía y empresas | Pág. 11
Viñateros adelantan dificultad para fiscalizar producción de vino ante nueva normativa

Nacional | Pág. 8
Dignidad humana y derecho a la vida
Nacional | Pág. 8
BAJA LA OCUPACIÓN DE CAMAS CRÍTICAS

Reportajes | Pág. 8
Aplicaciones robóticas capaces de decidir, la inteligencia artificial 2.0

Nacional | Pág. 8
Abogado de Torrealba: exalcalde pasó primera noche "complicada" en prisión
Reportajes | Pág. 7
Viene de la página anterior

Reportajes | Pág. 7
Patrimonio urbano y rasgos identitarios de Lota Alto
Reportajes | Pág. 7
Los Adler
Nacional | Pág. 7
Equipos Weiler de Finning: la solución más eficiente de la industria forestal

Economía y empresas | Pág. 11
Sence Biobío llama a parte de sus usuarios a actualizar datos bancarios por Pago Anual
Economía y empresas | Pág. 11
¿QUÉ DICE LA NORMATIVA?
Nacional | Pág. 7
Capacitar a operadores de maquinaria forestal es clave

Página del lector | Pág. 18
Aviones

Espectáculos | Pág. 20
Las ideas que brotan en el resurgir de la danza

Espectáculos | Pág. 20
Agencia Frenétika dijo presente en Primavera Sound 2023
Espectáculos | Pág. 19
Correo

Espectáculos | Pág. 19
Ezra Miller protagoniza la versión más nostálgica de "The Flash" entre polémicas

Espectáculos | Pág. 19
BTS tiñe de morado Seúl para celebrar sus diez años de vida

Página del lector | Pág. 18
Sudoku

Página del lector | Pág. 18
Fotoclick!

Página del lector | Pág. 18
Crucigrama

Página del lector | Pág. 18
Horóscopo

Deportes | Pág. 13
Lota Schwager debuta en Tercera B: "Los muchachos se sienten preparados"
Clasificados | Pág. 17
Las señales cerebrales podrían ser la clave para tratar el dolor crónico

Clasificados | Pág. 17
Cáncer de pulmón es la principal causa de muerte en Chile

Deportes | Pág. 14
Fórmula 1: GP de Canadá se corre hoy con Verstappen como favorito

Deportes | Pág. 14
Colo Colo recibe a Deportivo Cali pensando en el partido clave contra Pereira

Deportes | Pág. 14
Chile obtuvo buenos resultados en preolímpico de rugby seven

Deportes | Pág. 14
Berizzo destaca el juego de La Roja y espera replicarlo en su visita a Bolivia

Deportes | Pág. 14
Barrios quedó fuera en semifinales del Challenger de Bratislava

Deportes | Pág. 13
Un renovado Deportes Concepción tiene otra prueba ante el clásico rival

Deportes | Pág. 13
Naval volvió a los abrazos

Reportajes | Pág. 7
El viento conoce mi nombre

Reportajes | Pág. 6
"Escribo rodeada de mis fantasmas"
Reportajes | Pág. 2
400 nichos sumará el cementerio de Penco en su primera etapa

Reportajes | Pág. 2
Plan Biobío Se Levanta ha ejecutado 135 iniciativas de reconstrucción

Opinión | Pág. 3
90 años en la escena del crimen
Reportajes | Pág. 2
"
Reportajes | Pág. 2
"

Reportajes | Pág. 2
"

Reportajes | Pág. 2
Una Plaza para la Ciudadanía
Reportajes | Pág. 2
Traspasan recursos por crisis de la basura

Reportajes | Pág. 2
Temperatura llega a cero grados Celsius en la zona
Opinión | Pág. 2
Seguridad, roles y proyectos de ley

Reportajes | Pág. 2
Parlamentarios locales se reúnen con Boric por hechos en la Macrozona

Opinión | Pág. 3
Bianchi renunció a la testera de la Cámara
Opinión | Pág. 2
PDI detectó más de 65 puntos de venta de droga cerca de colegios

Opinión | Pág. 2
Locomoción colectiva amenaza con nueva paralización
Opinión | Pág. 2
Llamarán a nueva licitación para concluir obras en Maipú y Freire

Opinión | Pág. 2
Humor
Reportajes | Pág. 2
Entregan primera vivienda definitiva post incendios
Reportajes | Pág. 2
Biobío registra lenta vacunación contra influenza
Opinión | Pág. 2
Correo
Reportajes | Pág. 2
50% bajó el número de colmenas en Chiguayante

Opinión | Pág. 3
A dos años de la entrada en vigencia de la Ley de Entrevistas Videograbadas
Opinión | Pág. 3
Boluarte descarta adelantar elecciones

Actualidad | Pág. 6
PDI de Concepción detiene a prófugo por homicidio en Coronel

Reportajes | Pág. 4
Daniela Melian Antulafken, a 56 días del accidente aéreo que cambió su vida

Actualidad | Pág. 6
Gore entregó respiradores autónomos a compañías de Bomberos del Biobío

Actualidad | Pág. 6
Defensor regional llama a corregir errores de causas para "garantizar un sistema justo"

Actualidad | Pág. 6
Alianza permitirá afrontar impactos de los últimos incendios forestales

Reportajes | Pág. 5
La receta local para frenar el alza de virus respiratorios

Actualidad | Pág. 5
Expertos valoraron rol de la inteligencia militar en seguridad pública

Actualidad | Pág. 5
CESCRO USS organizó seminario sobre rol de FFAA en seguridad pública
Reportajes | Pág. 4
"Me he sentido abandonada en relación al apoyo psicológico"

Actualidad | Pág. 4
"El trabajo preventivo de toda la red asistencial no ha parado desde el tiempo de la pandemia"

Actualidad | Pág. 4
Ataque incendiario destruye dos cabañas en Cañete

Opinión | Pág. 3
Contraloría desmiente a ministra de Salud

Reportajes | Pág. 3
"A todos quienes estamos tratando de mover cambios desde el Gobierno nos anima la idea de la unidad"

Opinión | Pág. 3
Ucrania anuncia "liberación" de ciudades

Opinión | Pág. 3
Simce arroja histórica caída de 10 puntos

Opinión | Pág. 3
Muere Silvio Berluscuni a los 86 años
Opinión | Pág. 3
La inflación llega a 114% en Argentina

Opinión | Pág. 3
Investigarán filtración de audio de Boric
Opinión | Pág. 3
Fernando Araos dimite a la subsecretaría de Redes Asistenciales

Opinión | Pág. 3
El potencial de la inteligencia artificial para Chile

Opinión | Pág. 3
El expresidente Trump se declara "no culpable" tras ser procesado por 37 cargos
Espectáculos | Pág. 20
Una agencia Frenétika por la música de la Región del Biobío